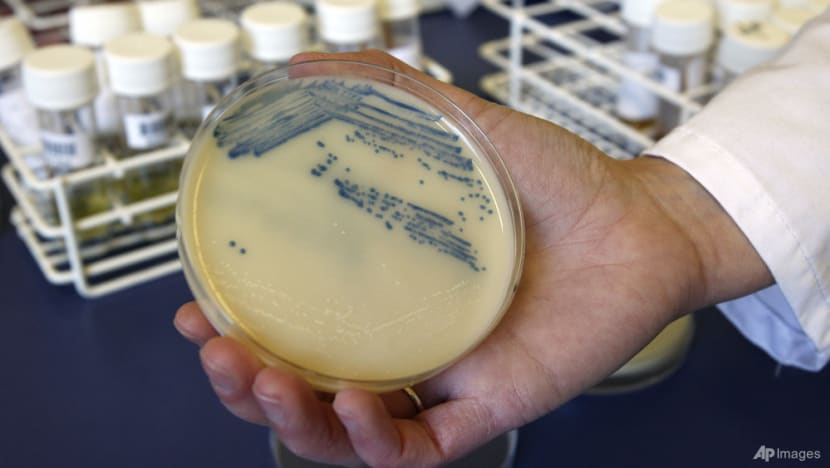

Commentary: We face a world potentially running out of antibiotics
Almost all infectious diseases physicians have had the dreaded call about patients with infections that were essentially untreatable because of antimicrobial resistance, says a Monash University professor.
This audio is generated by an AI tool.
MELBOURNE: These days, we don’t think much about being able to access a course of antibiotics to head off an infection. But that wasn’t always the case - antibiotics have been available for less than a century. Before that, patients would die of relatively trivial infections that became more serious.
Some serious infections, such as those involving the heart valves, were inevitably fatal. Other serious infections, such as tuberculosis, weren’t always fatal. Up to a half of people died within a year with the most severe forms, but some people recovered without treatment and the remainder had ongoing chronic infection that slowly ate away at the body over many years.
Once we had antibiotics, the outcomes for these infections were much better.
You’ve probably heard of Alexander Fleming’s accidental discovery of penicillin, when fungal spores landed on a plate with bacteria left over a long weekend in 1928.
But the first patient to receive penicillin was an instructive example of the impact of treatment. In 1941, Constable Albert Alexander had a scratch on his face that had become infected.
He was hospitalised but despite various treatments, the infection progressed to involve his head. This required removing one of his eyes.

Howard Florey, the Australian pharmacologist then working in Oxford, was concerned penicillin could be toxic in humans. Therefore, he felt it was only ethical to give this new drug to a patient in a desperate condition.
Constable Alexander was given the available dose of penicillin. Within the first day, his condition had started to improve.
But back then, penicillin was difficult to produce. One way of extending the limited supply was to “recycle” penicillin that was excreted in the patient’s urine. Despite this, supplies ran out by the fifth day of Alexander’s treatment.
Without further treatment, the infection again took hold. Constable Alexander eventually died a month later.
We now face a world where we are potentially running out of antibiotics - not because of difficulties manufacturing them, but because they’re losing their effectiveness.
WHAT DO WE USE ANTIBIOTICS FOR?
We currently use antibiotics in humans and animals for a variety of reasons. Antibiotics reduce the duration of illness and the chance of death from infection. They also prevent infections in people who are at high risk, such as patients undergoing surgery and those with weakened immune systems.
But antibiotics aren’t always used appropriately. Studies consistently show a dose or two will adequately prevent infections after surgery, but antibiotics are often continued for several days unnecessarily. And sometimes we use the wrong type of antibiotic.
Surveys have found 22 per cent of antimicrobial use in hospitals is inappropriate.
In some situations, this is understandable. Infections in different body sites are usually due to different types of bacteria. When the diagnosis isn’t certain, we often err on the side of caution by giving broad spectrum antibiotics to make sure we have active treatments for all possible infections, until further information becomes available.
In other situations, there is a degree of inertia. If the patient is improving, doctors tend to simply continue the same treatment, rather than change to more appropriate choice.
In general practice, the issue of diagnostic uncertainty and therapeutic inertia are often magnified. Patients who recover after starting antibiotics don’t usually require tests or come back for review, so there is no easy way of knowing if the antibiotic was actually required.
Antibiotic prescribing can be more complex again if patients are expecting “a pill for every ill”.
While doctors are generally good at educating patients when antibiotics are not likely to work (for example, for viral infections), without confirmatory tests there can always be a lingering doubt in the minds of both doctors and patients. Or sometimes the patient goes elsewhere to find a prescription.
For other infections, resistance can develop if treatments aren’t given for long enough. This is particularly the case for tuberculosis, caused by a slow growing bacterium that requires a particularly long course of antibiotics to cure.
As in humans, antibiotics are also used to prevent and treat infections in animals. However, a proportion of antibiotics are used for growth promotion. In Australia, an estimated 60 per cent of antibiotics were used in animals between 2005 and 2010, despite growth-promotion being phased out.
WHY IS OVERUSE A PROBLEM?
Bacteria become resistant to the effect of antibiotics through natural selection - those that survive exposure to antibiotics are the strains that have a mechanism to evade their effects.
For example, antibiotics are sometimes given to prevent recurrent urinary tract infections, but a consequence, any infection that does develop tends to be with resistant bacteria.
When resistance to the commonly used first-line antibiotics occurs, we often need to reach deeper into the bag to find other effective treatments. Some of these last-line antibiotics are those that had been superseded because they had serious side effects or couldn’t be given conveniently as tablets.
New drugs for some bacteria have been developed, but many are much more expensive than older ones.
TREATING ANTIBIOTICS AS A VALUABLE RESOURCE
The concept of antibiotics as a valuable resource has led to the concept of “antimicrobial stewardship”, with programmes to promote the responsible use of antibiotics. It’s a similar concept to environmental stewardship to prevent climate change and environmental degradation.
Antibiotics are a rare class of medication where treatment of one patient can potentially affect the outcome of other patients, through the transmission of antibiotic-resistant bacteria. Therefore, like efforts to combat climate change, antibiotic stewardship relies on changing individual actions to benefit the broader community.
Like climate change, antibiotic resistance is a complex problem when seen in a broader context. Studies have linked resistance to the values and priorities of governments such as corruption and infrastructure, including the availability of electricity and public services. This highlights that there are broader “causes of the causes”, such as public spending on sanitation and health care.
Other studies have suggested individuals need to be considered within the broader social and institutional influences on prescribing behaviour. Like all human behaviour, antibiotic prescribing is complicated, and factors like what doctors feel is “normal” prescribing, whether junior staff feel they can challenge senior doctors, and even their political views may be important.
There are also issues with the economic model for developing new antibiotics. When a new antibiotic is first approved for use, the first reaction for prescribers is not to use it, whether to ensure it retains its effectiveness or because it is often very expensive.
However, this doesn’t really encourage the development of new antibiotics, particularly when pharma research and development budgets can easily be diverted to developing drugs for conditions patients take for years, rather than a few days.
THE SLOW MOVING PANDEMIC OF RESISTANCE
Antibiotic resistance is already a problem. Almost all infectious diseases physicians have had the dreaded call about patients with infections that were essentially untreatable, or where they had to scramble to find supplies of long-forgotten last-line antibiotics.
There are already hospitals in some parts of the world that have had to carefully consider whether it’s still viable to treat cancers, because of the high risk of infections with antibiotic-resistant bacteria.
A global study estimated that in 2019, almost 5 million deaths occurred with an infection involving antibiotic-resistant bacteria. Some 1.3 million would not have occurred if the bacteria were not resistant.
The United Kingdom’s 2014 O'Neill report predicted deaths from antimicrobial resistance could rise to 10 million deaths each year, and cost 2 per cent to 3.5 per cent of global gross domestic product, by 2050 based on trends at that time.
WHAT CAN WE DO ABOUT IT?
There is a lot we can do to prevent antibiotic resistance. We can raise awareness that many infections will get better by themselves and don’t necessarily need antibiotics, and use the antibiotics we have more appropriately and for as short a time as possible, supported by coordinated clinical and public policy, and national oversight.
We can monitor for infections due to resistant bacterial to inform control policies and reduce the inappropriate use of antibiotics in animals, such as growth promotion. We can also reduce cross-transmission of resistant organisms in hospitals and in the community, and prevent infections by other means, such as clean water, sanitation, hygiene and vaccines.
We can also continue developing new antibiotics and alternatives to antibiotics and ensure the right incentives are in place to encourage a continuous pipeline of new drugs.
Allen Cheng is Professor of Infectious Diseases, Monash University. This commentary first appeared on The Conversation.